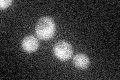
YDL115C
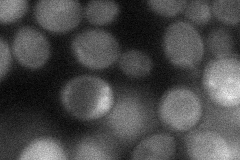
YDL115C
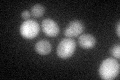
YDL115C
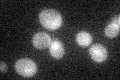
YDL115C

View description
Protein involved in transcription from polymerase II promoters; interacts with with most of the polymerase II subunits; nucleo-cytoplasmic shuttling protein; deletion causes hypersensitivity to the K1 killer toxin
Localization:
Intensity:
Fold change:
Significance:
-
C’ GFP library in SD
below threshold24.28 -
N' NOP1pr-GFP in SD

cytosol25.0353 -
N' TEF2pr-mCherry in SD

cytosol17.7645 -
N' NATIVEpr-GFP in SD

cytosol21.1288 -
N' TEF2pr-VC and Cyto-VN in SD
cytosol38.0752 -
C’ GFP library in SD+DTT
cytosol27.481.13No -
C’ GFP library in SD+H2O2

cytosol18.860.77No -
C’ GFP library in Starvation Media
cytosol28.241.16No -
C’ GFP library on the background of Pup2-DaMP

below threshold -
C’ GFP library on the background of CCT mutant

below threshold25.16061.03588No
